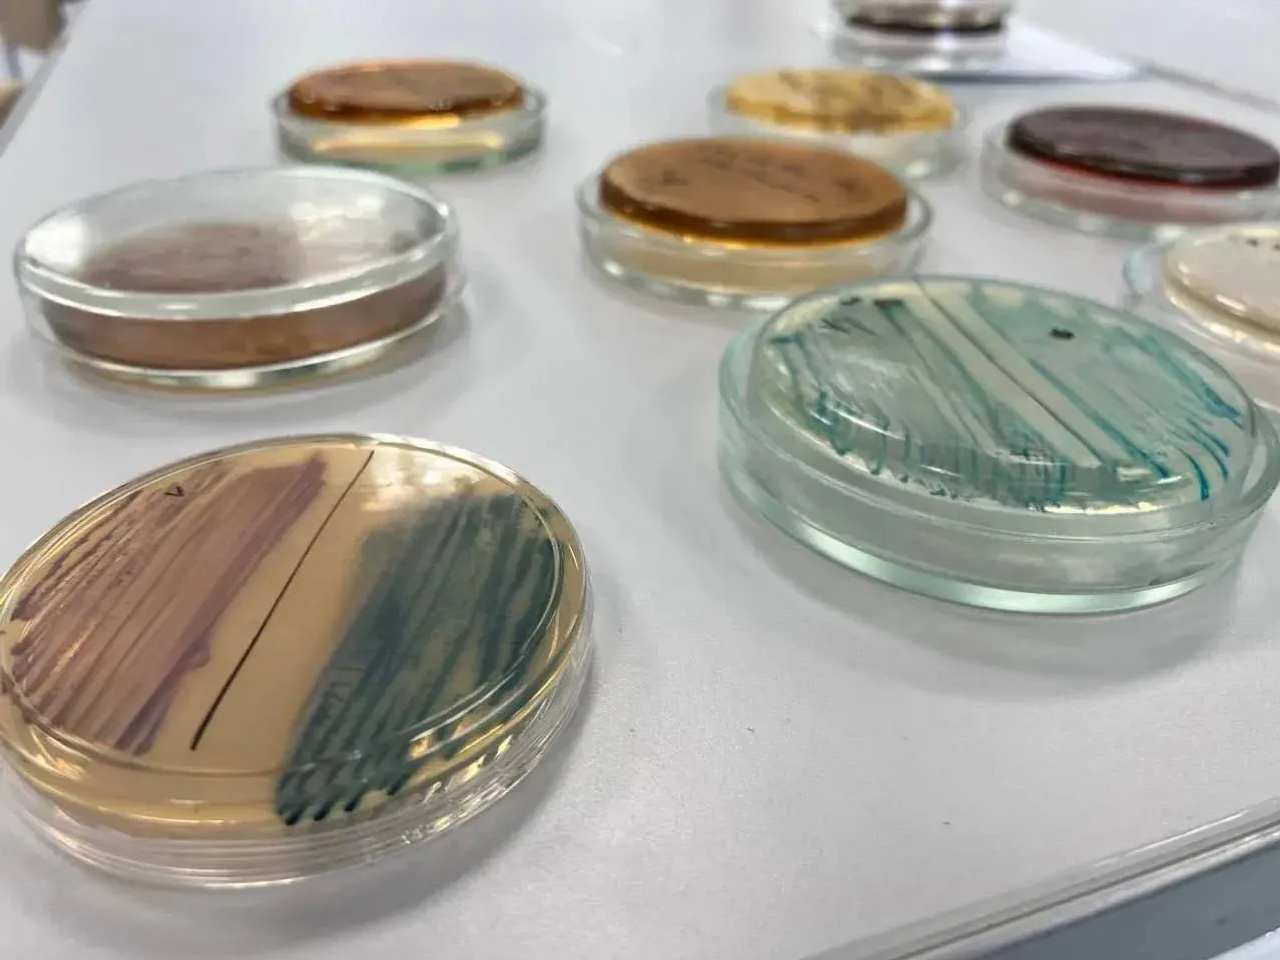
Тест на «бактерии стройности» из Башкортостана

Башҡортостан уҡытыусыһы
+14 °С
Облачно
Облачно
Новости
28 Марта , 14:05
Тест на «бактерии стройности» из Башкортостана
Исследователи лаборатории микробиома человека Башкирского медуниверситета разработали отечественную тест-систему, которая позволяет быстро и недорого определять количество бактерии Akkermansia muciniphila в организме человека. Её называют «бактерией стройности».


Тест на «бактерии стройности» из Башкортостана
Akkermansia muciniphila обитает в кишечнике здорового человека и составляет от 1 до 4% всей микробиоты. Её дефицит связан с ожирением, диабетом второго типа и воспалительными заболеваниями кишечника, а избыток может провоцировать онкологические заболевания.
Раньше для точного определения этой бактерии требовалось полногеномное секвенирование — процесс сложный и дорогой. Учёные БГМУ создали специальные нуклеотидные праймеры и зонды именно для этого вида. Новая тест-система работает по принципу ПЦР-тестов, но нацелена на конкретную бактерию.
Теперь мониторинг микробиоты становится доступным для клиник и научных центров. Разработка поможет врачам управлять микробиомом для профилактики социально значимых заболеваний.
Тест на «бактерии стройности» из Башкортостана